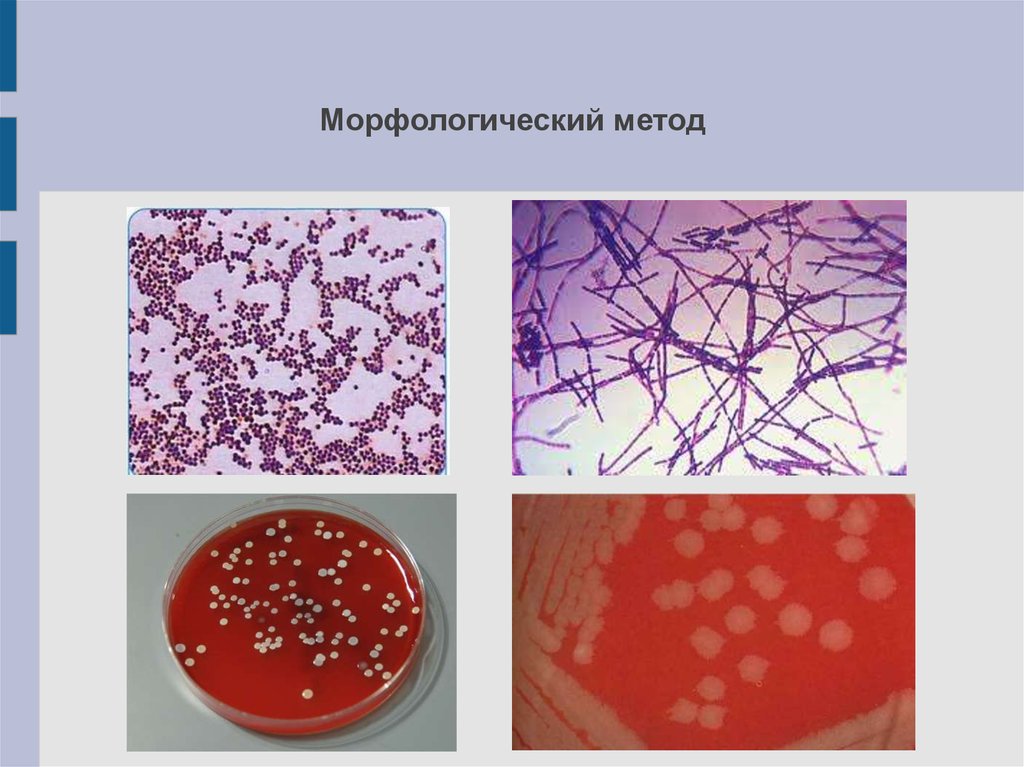
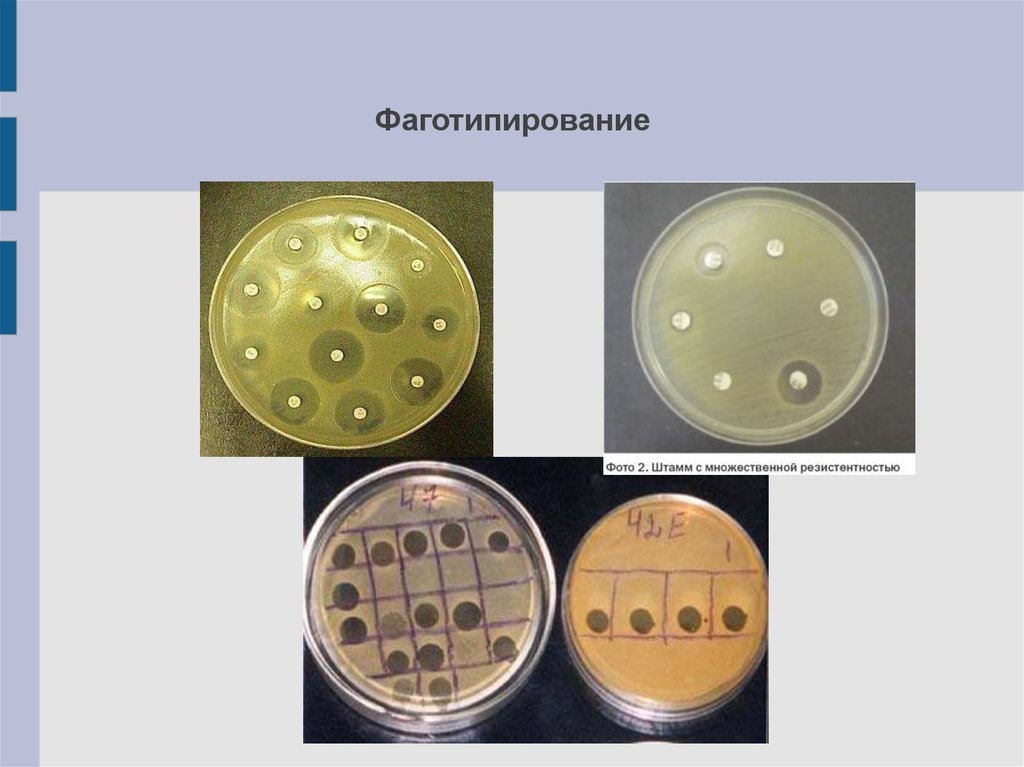

Similar presentations:
Методы внутривидового типирования микроорганизмов
1.
Методы внутривидового типирования микроорганизмов.2.
Группы методов:1) Морфологические
2) Фаготипирование
3)Серотипирование
4)Генотипировние
3.
Морфологический метод4.
Фаготипирование5.
СеротипированиеТипы антигинов:
Жгутиковые Н антигены
Соматические О антигены
Капсульные К антигены
Протекстивные антигены
6.
ГенотипированиеПрименяемые методы:
Рестрикционный анализ
ИФА
ПЦР
Молекулярная
гибридизация

biology
biology








